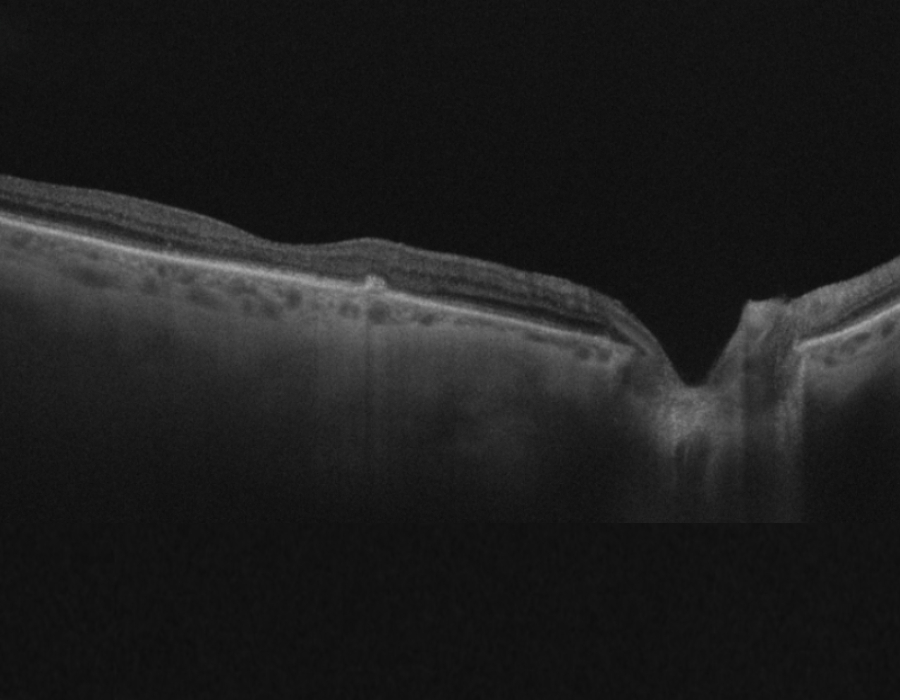
OCT image of retina of right eye with AMD after AntiVEGF injection

As a family from Dehradun, we had the privilege of experiencing exceptional care at Shroff Eye Centre ,Kailash colony ,Delhi for my 69-year-old mother's advanced Vitreo-Retinal(macular hole) surgery.
I'm overwhelmed with gratitude for the outstanding treatment she received.
Dr. Darius's expertise shines through in every aspect of his work, and his impressive qualifications, including being a Fellow of the Royal College of Surgeons, highlight his commitment to upholding the highest standards in surgery.
From the moment we stepped into the centre, the staff's professionalism and kindness impressed us. The liftman, nurses, reception counselors, and anesthetists were all courteous and efficient.
Dr. Darius's skill, experience, and compassion gave us immense confidence throughout the surgery process. His team worked seamlessly together to ensure my mother's comfort and safety.
The centre's integrated computer system is also noteworthy, ensuring that all patient information is readily available and no detail is missed. This level of organisation and optimal use of technology clearly contributes to the high standard of care provided.
Although we had to travel far for the surgery, it was worth every bit.
I wholeheartedly recommend Shroff Eye Centre and Dr. Darius to anyone seeking world-class eye treatment.
Their commitment to delivering exceptional patient care is truly commendable."
I give : 5/5 stars to Shroff eye centre
Your Eyes, Our Passion
AMD Treatment in Delhi NCR at Shroff Eye Centre

Overview
Treatment for AMD depends on the stage and type of Age related macular degeneration (AMD). Right now, there is no cure for AMD and treatment is aimed at preserving vision and preventing further visual loss. Lifestyle modifications and regular dilated eye checkups are important in treatment of AMD.
Content
Treatment of Dry Age-related Macular Degeneration (Dry AMD)
Depending on severity, Dry AMD is considered early, intermediate or late. In Dry AMD, vision loss is slower and likely due to age related thinning of the macula often accompanied by deposition of yellow protein clumps called Drusen in the macula.
Early AMD
In early AMD, Your retina specialist will ask you to follow up regularly. No intervention is needed at this stage. Apart from regular dilated eye checkups, patients are also encouraged to use the Amsler Chart periodically at home to keep a note of their symptoms. Lifestyle modifications must be made and sustained.
Intermediate AMD (AREDS2)
In intermediate AMD, the AREDS 2 study (Age-Related Eye Disease Study 2) found that special dietary supplements (vitamins & minerals) in a specific dosage may help slow down vision loss and stop it from turning into late AMD. If you have late AMD in only 1 eye, these supplements may slow down AMD in your other eye. These are
- Vitamin C (ascorbic acid) 500 mg
- Vitamin E 400 international units (IU)
- Lutein 10 mg
- Zeaxanthin 2 mg
- Zinc (as zinc oxide) 80 mg
- Copper (as cupric oxide) 2 mg
New Treatment for late Dry AMD or Geographic atrophy
For Late stage Dry AMD, also called Geographic atrophy, there was no treatment available till recently.
Recently, two new FDA-approved medications for Geographic atrophy - Pegcetacoplan (SYFOVRE) and Avacincaptad pegol (Izervay) have become available. These are given as injections in the eye (intravitreal) and have been shown to slow down the development of geographic atrophy or late dry AMD. They do not improve vision or cure AMD.
They work by blocking the complement cascade- a part of the immune system which is involved in inflammation- and stop the complement pathway from attacking the retina in AMD.
Their side effects include light sensitivity, eye pain, rise in eye pressure and eye inflammation. Which is why these medications are meant for very specific cases and your retina specialist will discuss the risk benefit ratio with you.
These drugs are also not yet approved for use in late stage Age related Macular degeneration in India.
Treatment of Wet Age-related Macular Degeneration (Wet AMD)
Wet AMD is an advanced form of AMD and usually affects vision. While there is no cure for wet AMD yet, there are 2 treatment options that may slow down or stop vision loss from wet AMD:
- Anti-VEGF injections: medication directly given as injections into the eye. Read below for more information
- Photodynamic therapy: a combination of injections and laser treatment. Read below for more information
Your retina specialist will choose a treatment strategy after doing a thorough eye exam.
Anti-VEGF injections for wet macular degeneration
Anti-VEGFs are medicines which block VEGF or Vascular endothelial growth factor. This blocks the development of new abnormal blood vessels in your retina and prevents bleeding in your eye- which usually happens in wet AMD.
These are given as injections into the eye and are usually required at regular intervals. The medicines used are:
- Aflibercept (Eylea®)
- Ranibizumab (Lucentis®)
- Bevacizumab (Avastin®)
- Faricimab (VABYSMO®)
- Brolucizumab (Beovu®)
You do not need to stay in the hospital after Anti-VEGF injections are given. Usually, we keep you under observation for some time and then you can return home as it is a day-care procedure requiring short admission.
Photodynamic therapy for wet macular degeneration
Photodynamic therapy is not often used now and may be reserved for specific cases such as polypoidal choroidal vasculopathy (PCV). In this, a laser light activated drug is used. The laser activates the drug close to the blood vessels.
Newer treatments in Wet AMD
- Some of the newer Anti-VEGFs are longer lasting so patients don't need to take them as often. Faricimab (VABYSMO®) targets both VEGF and the protein angiopoietin-2 and due to its longer lasting action can be taken less frequently.
- New formulation of Aflibercept (Eylea HD) quadruples the dose of the traditional treatment. This means it can last up to 3 to 4 months as compared to the standard-dose version so patients don’t need it every month.
Lifestyle modifications for Age related Macular Degeneration
Along with treatment, lifestyle modifications are important as they help slow down disease progression in AMD. In some studies it’s also shown to reduce the occurrence of AMD. These are especially important in people with a family history of AMD. Lifestyle modifications which help are:
- Quitting smoking- has a big impact on disease outcomes
- Eating a well balanced diet rich in anti-oxidants including vitamins and minerals
- Regular exercise- physical activity for 1-2 hours everyday
- Control co-morbidities- managing weight, diabetes, high blood pressure and lipid levels help slow down progression in AMD
Regular eye checkups in AMD
- Regular eye checkups with your retina specialist are important and must not be missed even if you feel your vision is normal.
- A full dilated eye exam helps keep a close watch on AMD and helps identify disease progression early.
- Along with this, patients are encouraged to routinely use the Amsler’s grid even at home to keep a watch on their vision. Changes in vision is a sign of progression in AMD.
Living with AMD
A diagnosis of AMD can be overwhelming, especially if it has progressed to a later stage. Other than vision loss patients have to navigate the emotional burden of a chronic disease. AMD affects central vision and even with wet AMD, peripheral vision is not affected (if there’s no other coexisting eye problem).
With timely treatment, lifestyle modifications and visual rehabilitation, most patients are able to largely lead their lives independently.
- Low vision Aids for AMD: Magnifying glasses, magnifying accessibility apps in phones and high contrast lighting are helpful.
- Digital resources for AMD: voice-to-text apps, screen readers, voice activated appliances, facial recognition software and digital assistants make life easier in AMD. Newer devices such as the AI powered glasses may help identify people and objects in front of you.
- Occupation therapy for AMD: to help you move and adapt to your environment with your changed vision. Installation of high contrast flooring, non-slip surfaces, step-free homes and good lighting will help those with AMD live better. Honing other senses such as touch, smell and learning how to use the peripheral vision will be to your advantage.
- Social and emotional support: Seek professional mental health help and connect with your support group, family or friends. It may help you cope better.
- Healthy living with AMD: Exercising daily, eating a blanched diet rich in anti-oxidants, and stopping smoking will help in AMD.
- Regular eye checkups: Once you’ve been diagnosed with AMD, you have to be on lifelong follow up and visit your ophthalmologist for regular eye checkups. This makes sure any progression is caught early.
New Research in AMD treatment
Photobiomodulation (PBM) therapy
PBM therapy received FDA authorization in 2024 for treating dry AMD. It is a non-invasive treatment of dry AMD with exposure to multiple wavelengths of light. It has shown great potential- early data from Phase 3 clinical trials showed vision improvement and reduced geographic atrophy progression. However, bigger studies and adoption in real world scenarios will be able to tell us about long term benefits as well as long-term safety and efficacy.
Stem cell therapy for Dry AMD
Researchers are studying if stem cells can help replace the retinal cells lost in dry AMD and thus restore vision. Stem cell therapy is not available for commercial use anywhere in the world and is still under investigation.
Gene Therapy for Wet AMD
Gene therapy is an exciting new field and researchers are studying ways to be able to activate the body's own Anti-VEGF so it can stop the abnormal vessels from growing in wet AMD. Gene therapy’s long term effectiveness is not yet known and when such a treatment is approved for use, it will likely be very expensive and not meant to treat all cases of wet AMD.
FAQs
What is AMD?
AMD is one of the major causes of blindness in people >50 years of age. In this condition, the macula, which is the central part of the retina, gets affected and its cells start degenerating. AMD is progressive, i.e. the vision may keep worsening gradually, leading to loss of central vision which is responsible for the details in our vision. It requires regular monitoring to ensure timely treatment to try and preserve vision. Read more about AMD here
Does Shroff Eye Centre offer treatment for AMD?
Shroff Eye Centre’s vitreo-retina team is widely recognized as amongst the best in India. We regularly diagnose and treat hundreds of patients with AMD (Age-related macular degeneration) every month. Intravitreal Anti-VEGF injections are regularly given by our retina specialist at our eye centres in Delhi, Gurugram and Ghaziabad. Vabysmo and newer anti-VEGFs are also available at Shroff Eye Centre. To meet our retina specialists please call 9910956780.
What is the cost of AMD treatment at Shroff Eye Centre?
The cost of treatment depends on what treatment you would need.
- In early AMD you only need regular follow-ups.
- In intermediate AMD you have to take special supplements which you can purchase.
- The treatment for wet AMD is Anti-VEGF injections whose package costs start from Rs. 35000 at Shroff Eye Centre.
Please call 9910956780 for details of our retina consultation, diagnostic charges and latest AMD treatment cost.
Are Anti-VEGF injections for AMD covered under health insurance?
Most health insurance does cover intravitreal injections for AMD. However, this may differ from policy to policy and we recommend that you check the terms and conditions of your policy and confirm with your insurance provider as well.
Is there a cure for Age-related Macular Degeneration (AMD)?
As of 2025, there is no cure for AMD but treatment to slow down progression of AMD, preserve vision, and in some cases of wet AMD even improve vision, does exist. Early detection and treatment are important for better outcomes. Lots of research is ongoing to try to find a cure for AMD but no cure is yet available.
Do intravitreal Anti-VEGF injections work in wet AMD?
Yes, intravitreal Anti-VEGF injections do work in wet AMD and help slow down progression in most cases. In a few patients with wet AMD, they may even improve vision.
What is the procedure for Anti-VEGF injections for AMD?
Anti-VEGF injections are given in a minor OT under topical anaesthesia at Shroff Eye Centre. You do not need to stay overnight in the hospital and can head home after the injection. Read more about the process
Are eye injections painful?
Most patients report minimal discomfort during eye injections (also known as intravitreal injections) as the eye is numbed with topical anesthetic drops. Some patients may experience mild pressure or brief stinging, but the procedure takes only seconds. After the injections, a few patients report a little redness/congestion which usually disappears in 24–36 hours.
How many eye injections will I need?
This depends on the stage of your AMD and your response to treatment. Usually, treatment typically tailored as per the need of the eye, it can involve monthly injections (loading dose) for a few months, followed by maintenance dose by extending the intervals between injections. Some patients may need injections as frequently as every 4-6 weeks, while others may go longer between treatments. Newer Anti-VEGFs also allow for a longer time gap between injections.
What is the red dot on my eye after the injection?
This is usually nothing to worry about and just the point where the needle entered the eye. It usually heals on its own in a few days.
I am seeing worse after my eye injection, what should I do?
If you experience severe or persistent pain, feel like there is a drop in vision or a sudden increase in floaters- please come show your retina specialist immediately. They will check if everything is ok. Patients of Shroff Eye Centre may call 011-41633999 or contact the emergency phone number provided on discharge.
Will blue light blocking lenses slow down my AMD?
Current evidence does not support the use of blue light blocking lenses or filters for consumer devices such as mobiles or computer screens. Compared to other risk factors for AMD such as aging, smoking, being overweight, having cardiovascular problems, blue light from consumer devices has minimal risk. Current studies do not indicate that blue light from consumer devices causes or worsens AMD.
What should I do if I notice vision changes?
If you notice any sudden change in your vision, please don't wait. Get in touch with us or your retina specialists immediately. Some symptoms which need an urgent eye check-up are:
- Sudden vision changes
- Distorted lines or shapes
- New blind spots
- Sudden increase in floaters and flashes
- Significant changes in color perception
Retina Patient Testimonials
See the Difference
Why Shroff Eye Centre?
1
Excellence
in Eyecare since 1914
2
Award winning
Eye specialists
3
Empathetic
Personalised patient care
4
Advanced care
1 lac happy eyes / year
5
Ethical
Patient-first approach
Patient Reviews
Great experience from the reception till departure. Dr. Cyrus is a great clinician and retina expert, thorough and reassuring. Indeed an authority in the subject. Thanks.
I had an excellent experience with Dr. Gagan Bhatia retina specialist. From the moment I walked in, the staff was warm and professional. Dr. Gagan Bhatia took the time to explain my condition in detail, answered all my questions patiently, and made sure I felt at ease throughout the process. The treatment was smooth, and I noticed a clear improvement in my vision. I highly recommend anyone with retina issues to visit them — truly an expert in the field.
I had a wonderful experience with Dr. Gagan Bhatia. He is not only highly skilled but also extremely patient and understanding. He took the time to explain my condition in detail, answered all my questions, and made me feel completely at ease throughout the treatment process. His expertise as a retina specialist is evident, and I felt confident and well cared for at every step. The staff was also very supportive, and the clinic was well-organized. I truly appreciate his professionalism and compassion and would highly recommend Dr. Gagan Bhatia to anyone seeking expert eye care.
I had a retina surgery and developed a glaucoma and then cataract , as with the young age it’s too dark time to go thru , but then some how I got a reference of DR. JASLEEN from Dr.Shroff centre kaushambi and got operated cataract on one of my eye . I should address here , that she is such a great expertise ,to me as a patient she was so polite to attend calls whenever I call her due to sudden phobia of eye treatments . Dr .jasleeen is most amazing and wonderful doctor . Still my routine check up is continuing with her . She is such a sweet as a person and as professional . And yes outcome of surgery is amazing and superb .
AMD Treatment Near You
Kailash Colony
A-9, Lala Lajpat Rai Rd, Block A, Kailash Colony, Greater Kailash, New Delhi, Delhi 110048
South Delhi areas- Greater kailash, Lajpat nagar, Cr park, Defence colony, Niti bagh, Saket, Noida
GET DIRECTIONS
Connaught Place
Building (1st floor, 105, Surya Kiran, 19, KG Marg, New Delhi, Delhi 110001
Central Delhi- serving Karol bagh, Rajender Nagar, Civil lines
GET DIRECTIONS
Gurgaon
110 Bestech Chambers Radisson Suites, Block B, Sector 27, Gurugram, Haryana 122009
Haryana- Golf course road, Cyber city, Rewari, Sohna, Faridabad
GET DIRECTIONS
Ghaziabad
509, KM Trade Tower, adjacent to Radisson Blu, Sector 14, Kaushambi, Ghaziabad, Uttar Pradesh 201010
GET DIRECTIONS
Uttar Pradesh- Greater Noida, Ghaziabad, Merut, Bulandshahr, Hapur
Medical content reviewed by Shroff Eye Centre.
Updated : October 2025
Disclaimer
This is not medical advice. Your ophthalmologist will help you decide which procedure and lens is best suited for your eyes. Every patient and eye is different and thus the experience for every patient is variable.
All product and company names are trademarks or registered trademarks of their respective holders. Use of them does not imply any affiliation or endorsement by them.

By being on the website, your personal data is being processed for communication with you and providing services. We use cookies to collect and analyse information on site performance, usage, enhancement of customer usability and improvising the website. We have put in place terms of use,
By clicking on accept you agree to all the policies mentioned above. You can read more about them by clicking on read more and accept them individually.






 Call us
Call us Email us
Email us







